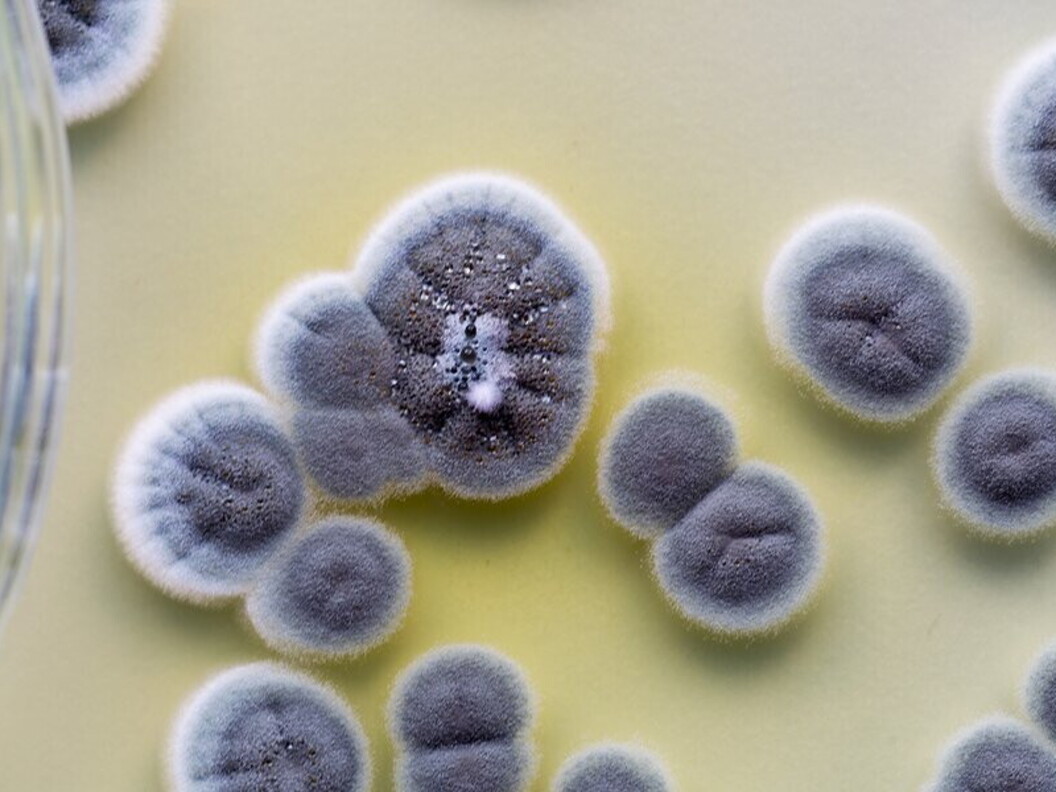
Penicillium
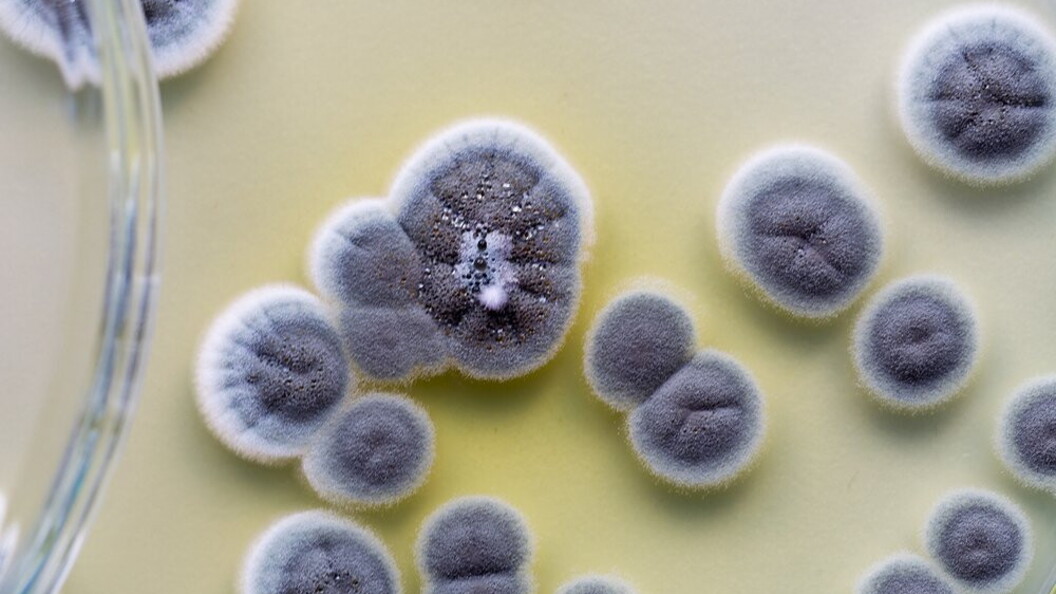
Penicillium

Penicillium
L’uomo conosce i batteri da poco tempo perché le loro minuscole dimensioni ne hanno reso possibile l’osservazione e lo studio solo dopo l’invenzione del microscopio. Il primo studioso che osservò e descrisse i batteri fu Anton van Leeuwenhoek (1632-1723). Era un mercante di stoffe che viveva in Olanda e usava lenti di ingrandimento per valutare la qualità delle stoffe. Nel 1668, durante un viaggio di affari in Inghilterra, acquistò alcune lenti molto potenti con le quali costruì un rudimentale microscopio. La sua curiosità lo spinse a osservare un po’ di tutto e fu così che casualmente vide per la prima volta i microbi.